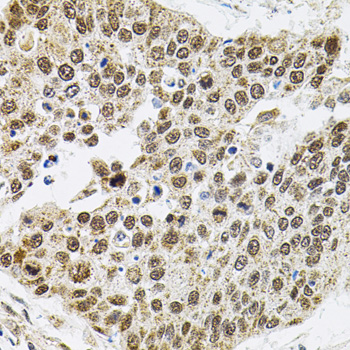
Immunohistochemistry - BAF60a Polyclonal Antibody

-
Product Name
BAF60a Polyclonal Antibody
- Documents
-
Description
Polyclonal antibody to BAF60a
-
Tested applications
WB, IHC
-
Species reactivity
Human, Mouse, Rat
-
Alternative names
SMARCC1 antibody; BAF155 antibody; CRACC1 antibody; Rsc8 antibody; SRG3 antibody; SWI3 antibody; SWI/SNF complex subunit SMARCC1 antibody
-
Isotype
Rabbit IgG
-
Preparation
Antigen: Recombinant fusion protein containing a sequence corresponding to amino acids 1-120 of mouse BAF60a (NP_114030.2).
-
Clonality
Polyclonal
-
Formulation
PBS with 0.02% sodium azide, 50% glycerol, pH7.3.
-
Storage instructions
Store at -20℃. Avoid freeze / thaw cycles.
-
Applications
WB 1:500 - 1:2000
IHC 1:50 - 1:200 -
Validations

Western blot - BAF60a Polyclonal Antibody
Western blot analysis of extracts of various cell lines, using Smarcd1 antibody at 1:1000 dilution.Secondary antibody: HRP Goat Anti-Rabbit IgG (H+L) at 1:10000 dilution.Lysates/proteins: 25ug per lane.Blocking buffer: 3% nonfat dry milk in TBST.Detection: ECL Basic Kit .Exposure time: 15s.

Immunohistochemistry - BAF60a Polyclonal Antibody
Immunohistochemistry of paraffin-embedded rat brain using Smarcd1 antibody (40x lens).

Immunohistochemistry - BAF60a Polyclonal Antibody
Immunohistochemistry of paraffin-embedded human lung cancer using Smarcd1 antibody (40x lens).

Immunohistochemistry - BAF60a Polyclonal Antibody
Immunohistochemistry of paraffin-embedded mouse brain using Smarcd1 antibody (40x lens).

Immunohistochemistry - BAF60a Polyclonal Antibody
Immunohistochemistry of paraffin-embedded rat brain using Smarcd1 antibody at dilution of 1:100 (40x lens).
Immunohistochemistry - BAF60a Polyclonal Antibody
Immunohistochemistry of paraffin-embedded human lung cancer using Smarcd1 antibody at dilution of 1:100 (40x lens).

Immunohistochemistry - BAF60a Polyclonal Antibody
Immunohistochemistry of paraffin-embedded mouse brain using Smarcd1 antibody at dilution of 1:100 (40x lens).
-
Background
Involved in transcriptional activation and repression of select genes by chromatin remodeling (alteration of DNA-nucleosome topology). Component of SWI/SNF chromatin remodeling complexes that carry out key enzymatic activities, changing chromatin structure by altering DNA-histone contacts within a nucleosome in an ATP-dependent manner. Belongs to the neural progenitors-specific chromatin remodeling complex (npBAF complex) and the neuron-specific chromatin remodeling complex (nBAF complex). During neural development a switch from a stem/progenitor to a postmitotic chromatin remodeling mechanism occurs as neurons exit the cell cycle and become committed to their adult state. The transition from proliferating neural stem/progenitor cells to postmitotic neurons requires a switch in subunit composition of the npBAF and nBAF complexes. As neural progenitors exit mitosis and differentiate into neurons, npBAF complexes which contain ACTL6A/BAF53A and PHF10/BAF45A, are exchanged for homologous alternative ACTL6B/BAF53B and DPF1/BAF45B or DPF3/BAF45C subunits in neuron-specific complexes (nBAF). The npBAF complex is essential for the self-renewal/proliferative capacity of the multipotent neural stem cells. The nBAF complex along with CREST plays a role regulating the activity of genes essential for dendrite growth (By similarity). Has a strong influence on vitamin D-mediated transcriptional activity from an enhancer vitamin D receptor element (VDRE). May be a link between mammalian SWI-SNF-like chromatin remodeling complexes and the vitamin D receptor (VDR) heterodimer. Mediates critical interactions between nuclear receptors and the BRG1/SMARCA4 chromatin-remodeling complex for transactivation.
Related Products / Services
Please note: All products are "FOR RESEARCH USE ONLY AND ARE NOT INTENDED FOR DIAGNOSTIC OR THERAPEUTIC USE"
